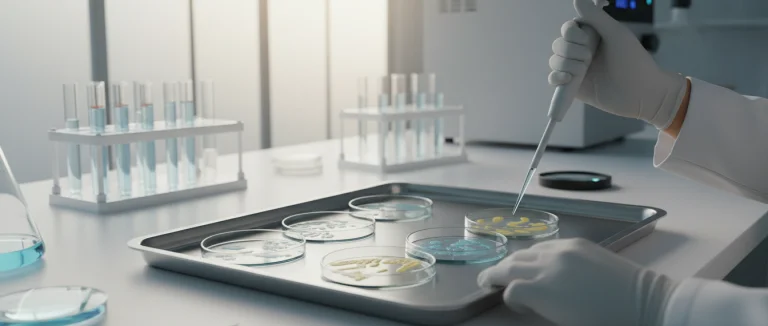
Лабораторный анализ мочи

Бактерии в моче: причины, диагностика и лечение | Лив Хоспитал
-
Причины появления бактерий в моче
-
Симптомы и признаки инфекции мочевых путей
-
Диагностика: как определить наличие бактерий в моче
-
Лечение и профилактика: что делать при обнаружении бактерий в моче
-
Риски осложнений при несвоевременном лечении
-
Почему выбирают Лив Хоспитал
Наличие бактерий в моче часто является первым сигналом о возможной инфекции мочевых путей (УИ). Эта проблема затрагивает миллионы людей по всему миру, и своевременное распознавание её признаков может предотвратить развитие серьёзных осложнений, таких как почечная инфекция. В статье мы разберём, какие факторы способствуют появлению бактерий в моче, как правильно диагностировать их присутствие и какие современные методы лечения предлагает Лив Хоспитал.
По данным Всемирной организации здравоохранения, более 150 миллионов человек ежегодно сталкиваются с инфекцией мочевых путей. Большинство случаев вызываются бактериями Escherichia coli, однако в ряде ситуаций могут участвовать и другие микроорганизмы. Понимание механизмов заражения помогает выбрать оптимальную стратегию профилактики и терапии.
Мы рассмотрим типичные причины появления бактерий, характерные симптомы, современные диагностические подходы и эффективные варианты лечения, включая антибиотики, пробиотики и рекомендации по образу жизни. Кроме того, вы узнаете, когда стоит обратиться в специализированный центр, такой как Лив Хоспитал, для получения высококвалифицированной помощи.
Причины появления бактерий в моче
Основные факторы, способствующие росту бактерий в моче, включают анатомические особенности, нарушения иммунитета и образ жизни. Ниже перечислены наиболее часто встречающиеся причины:
- Неполное опорожнение мочевого пузыря, часто наблюдаемое у мужчин с простатитом.
- Нарушения в работе мочеиспускательного канала, такие как стриктуры уретры.
- Снижение иммунитета после перенесённых заболеваний или при хронических состояниях.
- Неправильная гигиена, особенно у женщин, где близкое расположение анального и уретрального отверстий повышает риск переноса кишечных бактерий.
- Сексуальная активность без надлежащей защиты.
- Использование катетеров или других инвазивных медицинских процедур.
Кроме того, некоторые пищевые привычки могут влиять на микрофлору мочевого тракта. Высокий уровень сахара в крови при диабете создает благоприятную среду для размножения бактерий, а употребление слишком большого количества кофеина может раздражать мочевой пузырь, способствуя задержке мочи.
Важно отметить, что наличие бактерий в моче не всегда сопровождается ярко выраженными симптомами. В некоторых случаях обнаруживается лишь при лабораторном исследовании, что подчёркивает необходимость регулярных проверок, особенно у людей с предрасположенностью к УИ.

Симптомы и признаки инфекции мочевых путей
Когда бактерии начинают активно размножаться в мочевом тракте, появляются характерные симптомы УИ. Наиболее типичные проявления включают:
- Жжение и боль при мочеиспускании.
- Частое позывы к мочеиспусканию, иногда в небольших количествах.
- Боль в нижней части живота или в пояснице.
- Помутнение мочи, иногда с неприятным запахом.
- Повышенная температура тела и общее недомогание при распространении инфекции на почки.
У женщин симптомы часто проявляются быстрее из‑за более короткой уретры. У мужчин инфекция может сопровождаться болями в простате и более тяжёлым течением. Если в моче обнаруживается pyuria (наличие лейкоцитов), это указывает на воспалительный процесс.
Важно различать симптомы простых раздражений от настоящей инфекции. При появлении боли, частых позывов и изменения цвета мочи рекомендуется как можно быстрее пройти обследование, чтобы исключить развитие более серьёзных осложнений, таких как пиелонефрит.

Диагностика: как определить наличие бактерий в моче
Точная диагностика позволяет подобрать эффективное лечение и избежать ненужного применения антибиотиков. Основные методы выявления бактерий в моче включают:
| Метод | Принцип действия | Показатели | Время получения результата |
|---|---|---|---|
| Общий анализ мочи (ОАМ) | Определение наличия лейкоцитов, бактерий, эритроцитов | Положительный результат при >10 000 КОЕ/мл | 30–60 минут |
| Посев мочи | Культивирование бактерий для идентификации штамма | Определение чувствительности к антибиотикам | 24–48 часов |
| Молекулярные тесты (PCR) | Выявление ДНК патогенов | Высокая точность, быстрый результат | 2–4 часа |
Для точного определения причины инфекции врач может также назначить ультразвуковое исследование почек, особенно если есть подозрение на распространение инфекции. При повторных или хронических случаях часто используют комбинированный подход: общий анализ + посев + ультразвук.
Важно помнить, что самолечение без подтверждения наличия бактерий может привести к развитию резистентности к антибиотикам. Поэтому любые назначения должны базироваться на результатах лабораторных исследований.
Лечение и профилактика: что делать при обнаружении бактерий в моче
Эффективное лечение начинается с правильного выбора антибиотиков при УИ, основанного на результатах посева. Наиболее часто применяемые препараты включают фосфомицин, нитрофурантоин и препараты из группы фторхинолонов. Дозировка и продолжительность курса подбираются индивидуально, обычно от 3 до 7 дней.
Помимо медикаментозной терапии, важны дополнительные меры:
- Увеличение потребления чистой воды (не менее 2 литров в день) для ускорения выведения бактерий.
- Приём пробиотиков, способствующих восстановлению нормальной микрофлоры кишечника и мочевого тракта.
- Избегание раздражающих веществ: кофеин, алкоголь, острые специи.
- Соблюдение правил личной гигиены, особенно у женщин.
- Регулярные профилактические осмотры при предрасположенности к повторным инфекциям.
Для пациентов с хронической рецидивирующей инфекцией может потребоваться более длительный курс профилактических антибиотиков под контролем врача. В некоторых случаях рекомендуется проведение иммуномодулирующих процедур, которые предлагает Лив Хоспитал в рамках комплексных программ восстановления.
Риски осложнений при несвоевременном лечении
Если инфекцию не лечить своевременно, бактерии могут распространиться из нижних отделов мочевого тракта в почки, вызывая пиелонефрит. Этот процесс сопровождается высокой температурой, болями в пояснице и возможным развитием сепсиса — опасного состояния, требующего неотложной госпитализации.
Другие потенциальные осложнения включают:
- Образование камней в почках из‑за длительного присутствия бактерий.
- Хроническое воспаление слизистой оболочки мочевого пузыря, приводящее к боли и частым рецидивам.
- Повреждение почечной ткани, что может привести к снижению функции почек.
- Развитие устойчивости к антибиотикам при неправильном приёме препаратов.
Особенно опасно игнорировать симптомы у людей с диабетом, беременных женщин и пожилых пациентов, у которых иммунитет ослаблен. При появлении признаков осложнений необходимо незамедлительно обратиться к врачу и пройти углублённое обследование.
Почему выбирают Лив Хоспитал
Лив Хоспитал – международный центр медицинского обслуживания, аккредитованный JCI, расположенный в Стамбуле. Мы предлагаем широкий спектр услуг для иностранных пациентов, включая полное обследование, диагностику и лечение инфекций мочевых путей с использованием передовых технологий. Наши специалисты обладают многолетним опытом работы с УИ, а современное оборудование обеспечивает точные результаты лабораторных исследований. Мы также предоставляем услуги переводчика, транспорт и помощь с размещением, делая процесс лечения максимально комфортным для пациентов из любой страны.
Если у вас обнаружены бактерии в моче или появились симптомы инфекции, запишитесь на консультацию в Лив Хоспитал уже сегодня. Мы гарантируем индивидуальный подход, современную диагностику и эффективное лечение, которое поможет быстро восстановить ваше здоровье.
Часто задаваемые вопросы
Бактерии в моче указывают на то, что микробиологический баланс нарушен и патогенные микроорганизмы начали размножаться в мочевом тракте. Наиболее частый возбудитель – Escherichia coli, но могут участвовать и другие виды. Причины появления включают неполное опорожнение мочевого пузыря, стриктуры уретры, использование катетеров, плохую гигиену, сексуальную активность без защиты, а также факторы, способствующие росту бактерий, такие как высокий уровень сахара в крови при диабете и избыточное потребление кофеина. При ослабленном иммунитете организм менее эффективно борется с микробами, что ускоряет развитие инфекции.
Симптомы инфекции мочевых путей могут различаться у мужчин и женщин. У женщин часто наблюдается более быстрое проявление из‑за короткой уретры: жжение, боль, частое небольшое мочеиспускание, неприятный запах и мутность мочи. У мужчин могут появляться боли в простате и более тяжёлое течение. При распространении инфекции на почки (пиелонефрит) появляются боли в пояснице, высокая температура, озноб и общее недомогание. Наличие лейкоцитов в моче (пюриа) также свидетельствует о воспалительном процессе.
Для подтверждения наличия бактерий в моче врач назначает общий анализ мочи (ОАМ), который выявляет лейкоциты, бактерии и эритроциты. При положительном результате часто проводят посев мочи, позволяющий определить конкретный штамм и его чувствительность к антибиотикам. Современные молекулярные тесты (PCR) обнаруживают ДНК патогенов с высокой точностью за несколько часов. При подозрении на осложнение могут быть назначены ультразвуковое исследование почек или КТ. Комбинированный подход (анализ + посев + УЗИ) повышает точность диагностики и помогает избежать ненужного применения антибиотиков.
После подтверждения инфекции врач подбирает антибиотик, учитывая чувствительность выявленного штамма. Чаще используют фосфомицин, нитрофурантоин или фторхинолоны, курс обычно 3‑7 дней. Важна адекватная гидратация – минимум 2 литра чистой воды в день, что ускоряет выведение бактерий. Пробиотики помогают восстановить нормальную микрофлору кишечника и мочевого тракта, снижая риск рецидивов. Рекомендуется избегать раздражающих факторов (кофеин, алкоголь, острые специи), соблюдать гигиену и при наличии предрасположенности проводить профилактические осмотры. При хронической инфекции могут потребоваться длительные профилактические курсы антибиотиков под контролем врача или иммуномодулирующие процедуры, которые предлагает Лив Хоспитал.
Для снижения риска рецидивов важно соблюдать личную гигиену, особенно у женщин – от передней к задней части при подмывании. Регулярное опорожнение мочевого пузыря, избегание задержки мочи и своевременное лечение заболеваний, таких как диабет, снижают благоприятную среду для бактерий. Пробиотики (Lactobacillus) поддерживают здоровую микрофлору. При необходимости использования катетеров следует применять стерильные материалы и ограничивать их время применения. Регулярные профилактические анализы мочи у людей с предрасположенностью позволяют выявлять инфекцию на ранних стадиях.
Лив Хоспитал – международный центр с аккредитацией JCI, расположенный в Стамбуле, специализируется на лечении инфекций мочевых путей. Центр использует передовые лабораторные методы (PCR, посев, УЗИ) для точной диагностики, а также предлагает индивидуальный подбор антибиотиков и дополнительные процедуры, такие как пробиотическая терапия и иммуномодуляция. Для иностранных пациентов предоставляются услуги переводчика, транспорт и помощь с размещением, что делает процесс лечения комфортным. Высококвалифицированные специалисты с многолетним опытом гарантируют эффективное и безопасное восстановление здоровья.
* Содержимое нашего сайта предназначено только для информационных целей. Обязательно обратитесь к врачу для диагностики и лечения. В содержание страницы не включены элементы, содержащие информацию о терапевтических медицинских услугах в Лив Госпитале.